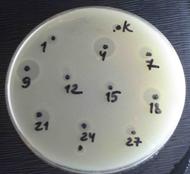

На правах рукописи
Антагонистическое действие пробиотических лактобактерий в отношении патогенных стрептококков различных
серологических групп
03.00.07 - Микробиология
АВТОРЕФЕРАТ
диссертации на соискание ученой степени
кандидата медицинских наук
Санкт-Петербург
2008
Работа выполнена в Отделе молекулярной микробиологии Государственного Учреждения Научно-исследовательский Институт экспериментальной медицины РАМН
Научный руководитель:
доктор медицинских наук, профессор Суворов Александр Николаевич
Официальные оппоненты:
доктор медицинских наук, профессор
доктор медицинских наук
Ведущая организация: Государственное образовательное учреждение высшего профессионального образования «Санкт-Петербургская государственная медицинская академия имени Федерального агентства по здравоохранению и социальному развитию»
Защита диссертации состоится 24 ноября 2008г. в 13 часов на заседании диссертационного совета ДМ при ГУ Научно-исследовательский институт РАМН Санкт-Петербург, ул. акад. Павлова, д. 12.
С диссертацией можно ознакомиться в научной библиотеке ГУ Научно-исследовательский институт РАМН Санкт-Петербург, ул. Академика Павлова, д. 12.
Автореферат разослан «…..» октября 2008г.
Ученый секретарь Диссертационного совета,
доктор медицинских наук
1. ОБЩАЯ ХАРАКТЕРИСТИКА РАБОТЫ
Актуальность проблемы. Заболевания, этиологически связанные с патогенными стрептококками и энтерококками, представляют в настоящее время одну из серьезных медицинских, социальных и экономических проблем здравоохранения. Стрептококки относятся к наиболее распространенным возбудителям бактериальных инфекций человека. Патогенные стрептококки, такие как S. pyogenes, S. agalactiae и S. pneumoniae, ассоциированы с тяжелыми формами острых и хронических инфекций. В то же время стрептококки других видов и энтерококки, персистирующие у лиц с иммунодефицитами, нередко являются причиной нозокомиальных инфекций (Schouten M. A. et al., 1999; Shankar N. L. et al., 2001).

Несмотря на высокую природную чувствительность стрептококков к антибиотикам некоторых классов, в ряде случаев антимикробная терапия ими может быть ограничена аллергическими проявлениями и развитием тяжелых форм дисбиозов. Кроме того, в последние десятилетия неуклонно растет распространенность антибиотикоустойчивых штаммов (Bass J. W. et al., 1991; Yang J. H. et al., 1996; Traub W. H. et al., 1997). Указанные проблемы диктуют необходимость не только рационального применения антибиотиков, но и сочетания их с безвредными средствами, обладающими антибактериальным и противовоспалительным действием. Использование с лечебно-профилактической целью пробиотических молочнокислых бактерий (лактобацилл и энтерококков) является одним из перспективных направлений подобного решения проблемы оздоровления населения. Пробиотические препараты на основе живых лактобацилл и энтерококков относятся к числу наиболее употребляемых вследствие их высокой антагонистической активности в отношении патогенной микрофлоры.
Пробиотики чаще используют для лечения и профилактики заболеваний, связанных с различными формами нарушения качественного и количественного состава нормальной микрофлоры желудочно-кишечного и урогенитального трактов. В связи с этим антагонистическая активность молочнокислых бактерий изучена в большей степени в отношении микроорганизмов, ассоциированных с дисбиотическими состояниями. В то же время данные об антибактериальном действии пробиотических молочнокислых бактерий в отношении патогенных стрептококков и энтерококков встречаются редко и, как правило, представляют собой сообщения об активности метаболитов лактобактерий в отношении отдельных штаммов стрептококков и энтерококков (Ross K. F. et al., 1993; Upton M. А. et al., 2001; Tagg J. R. et al., 2003). Кроме того, эти исследования носят качественный характер, так как доза антагониста, ингибирующая рост индикаторных энтерококков, не определялась. Таким образом, антимикробное действие пробиотических молочнокислых бактерий в отношении стрептококков и энтерококков остается недостаточно изученным. Это составляет определенную проблему, так как широкое применение лечебно-профилактических средств на основе живых молочнокислых бактерий требует четкого обоснования использования определенных доз препаратов в терапевтических и профилактических целях.
Анализ антимикробной активности пробиотических препаратов затруднен отсутствием единых стандартных подходов, которые могли бы быть использованы для оценки и сравнения антагонистического действия различных штаммов молочнокислых бактерий в отношении широкого спектра патогенных и условно-патогенных микроорганизмов. Известно, что антагонизм лактобацилл и энтерококков обусловлен продукцией метаболитов (органических кислот, перекиси водорода, лизоцима и др.) и бактериоцинов ( и др., 2002). Однако механизмы регуляции их синтеза, а также влияние на жизнеспособность и морфофункциональные свойства стрептококков и энтерококков остаются недостаточно освещенными.
Приведенные данные свидетельствует о высокой актуальности исследований, касающихся особенностей антимикробного действия пробиотических штаммов, разработки методов изучения ингибирующей активности лактобактерий и создания условий для максимального проявления активности пробиотиков в отношении возбудителей инфекций человека, в том числе обусловленных патогенными стрептококками и энтерококками.
Цель исследования – изучить особенности антагонистического действия пробиотических штаммов лактобацилл и энтерококков в отношении патогенных стрептококков.
Задачи исследований:
1. Изучить антагонистическую активность живых культур пробиотических молочнокислых бактерий (лактобацилл и энтерококков) в отношении штаммов стрептококков различных серологических групп и энтерококков, выделенных от больных с различными формами инфекции.
2. Оценить ингибирующее влияние супернатантов культур пробиотических молочнокислых бактерий на рост индикаторных штаммов стрептококков и энтерококков.
3. Изучить факторы микробного антагонизма пробиотических молочнокислых бактерий, используя молекулярно-генетические и биохимические методы.
4. Подобрать условия, способствующие повышению антагонистической активности пробиотических штаммов в системе in vitro.
Научная новизна
Впервые предложен метод, позволяющий качественно и количественно оценивать антагонизм молочнокислых бактерий против патогенных стрептококков. Изучено антимикробное действие пробиотиков в отношении 50 штаммов стрептококков и энтерококков, установлены штаммовые, а в случае стрептококков и групповые, отличия по чувствительности к антагонистическому влиянию лактобацилл и энтерококков. В штамме Enterococcus faecium L3 впервые показана экспрессия генов, кодирующих синтез бактериоцинов (энтероцинов А и В), а также факторов регулирующих их синтез. На примере бактериоциногенного штамма E. faecium L3 продемонстрировано, что добавление в питательную среду искусственно синтезированных специфичного пептида-индуктора, повышающего уровень экспрессии бактериоцинов, а также его аналогов, приводит к значительному увеличению ингибирующей активности пробиотика.
Практическая значимость работы
Исследования, проведенные на 5 пробиотических препаратах («Лактобактерин», «Витафлор», «Бифиформ», «Ламинолакт», «Линекс») с набором индикаторных культур стрептококков, показали, что данные препараты существенно различаются по силе и спектру антимикробного действия, что свидетельствует о необходимости индивидуального подбора пробиотических препаратов в лечебно-профилактических целях. Метод двухслойного агара может быть рекомендован для изучения антагонистических свойств пробиотиков. Продемонстрированный на примере штамма E. faecium L3 феномен индукции синтеза бактериоцинов может быть использован при разработке новых высокоэффективных пробиотических препаратов, включающих не только живые бактерии-антагонисты, но и специфические индукторы продукции бактериоцинов.
Основные положения, выносимые на защиту:
1. Штаммы стрептококков различных серологических групп и энтерококков обладают индивидуальной чувствительностью к антагонистическому действию пробиотических молочнокислых бактерий.
2. Низкомолекулярные пептидные фракции, выделенные из супернатанта E. faecium L3, способны подавлять рост патогенных стрептококков.
3. Штамм E. faecium L3 содержит гены трехкомпонентной сигнальной системы, ответственной за синтез бактериоцинов, с которыми связана антимикробная активность данного штамма.
4. Искусственно синтезированные пептиды-индукторы и их гомологи повышают антимикробную активность бактериоциногенных штаммов молочнокислых бактерий.
Апробация работы
По теме диссертации опубликовано 14 научных работ, в том числе двух статей в изданиях, рекомендованных ВАК России. Материалы исследований доложены и обсуждены на многих отечественных и международных научных совещаниях («XVI международном симпозиуме по стрептококкам и стрептококковым заболеваниям им. Ленсфильд», Палм Ков, Австралия, 2005; заседании Научно-практического общества эпидемиологов, микробиологов и паразитологов, Санкт-Петербург, Россия, 2006; международном конгрессе «Пробиотики, пребиотики, синбиотики и функциональные продукты питания. Фундаментальные и клинические аспекты», Санкт-Петербург, Россия, 2007; IX съезде Всероссийского общества эпидемиологов, микробиологов и паразитологов, Москва, Россия, 2007; 10-м Юбилейном Славяно-Балтийском научном форуме «Санкт-Петербург – Гастро-2008», Санкт-Петербург, Россия, 2008; международной конференции «Probiotics for the 3rd Millennium», Высокие Татры, Словакия, 2008; «XVII международном симпозиуме по стрептококкам и стрептококковым заболеваниям им. Ленсфильд», Порто Хели, Греция, 2008).
Личный вклад диссертанта
Основная часть исследований выполнена лично автором. Ряд микробиологических экспериментов проведен совместно с к. м.н. (ГУ НИИЭМ РАМН) и к. в.н. (СПбГАВМ). Выделение антимикробных пептидов из супернатанта энтерококков выполнялось при консультации сотрудников Отдела общей патологии и патофизиологии ГУ НИИЭМ РАМН к. б.н. , к. б.н. , к. б.н. Цветковой микроскопия ультраструктуры стрептококков выполнена д. б.н., проф. (, СПб). Пептиды-индукторы синтезированы к. х.н. (, СПб).
Структура и объем диссертации
Диссертационная работа изложена на 167 страницах и включает: введение, обзор литературы, материалы и методы, результаты собственных исследований и их обсуждение, общее заключение, выводы, список литературы. Текст диссертации иллюстрирован 36 рисунками и 15 таблицами. Список литературы включает 180 источников, из них 19 отечественных и 161 зарубежных.
2. МАТЕРИАЛЫ И МЕТОДЫ
В качестве антагонистов в работе использовали 5 штаммов пробиотических лактобактерий (Enterococcus faecium L3, Enterococcus faecium SF68, Enterococcus faecium М74, Lactobacillus plantarum 8Р-А3, Lactobacillus acidophilus D75-76, входящих в рецептуру пробиотических препаратов «Ламинолакт», «Бифиформ», «Линекс», «Лактобактерин», «Витафлор», соответственно), а также штамм Lactobacillus fermentum 65, выделенный из влагалища здоровой женщины. Индикаторными культурами служили 40 штаммов стрептококков (по 10 штаммов из серологических групп A, В, C и G) и 10 штаммов энтерококков, выделенные от больных с инфекционной патологией. В качестве дополнительной индикаторной культуры использовали штамм Listeria monocytogenes EGD. Для культивирования микроорганизмов использовали жидкие и плотные питательные среды: THB (Todd-Hewitt Broth), BHI (Brain-Heart Infusion), MRS для культивирования лактобактерий, колумбийский агар с 10% нормальной лошадиной сыворотки, среду Мюллера-Хинтона, триптозный агар. Все штаммы инкубировали в аэробных условиях при 37оС.
Антагонизм молочнокислых бактерий в отношении патогенных стрептококков изучали с использованием модифицированного метода двухслойного агара ( и др., 2004), определяя при этом минимальную ингибирующую дозу антагониста (МИКА).
Антимикробное действие продуктов, секретируемых пробиотическими бактериями в жидкую среду, изучали посредством турбидометрического метода, наблюдая за изменениями оптической плотности (ОD640) растущих индикаторных культур при добавлении к ним супернатантов молочнокислых бактерий и полученных из них пептидных экстрактов.
Для определения способности лактобактерий продуцировать перекись водорода использовали методику, основанную на взаимодействии этого химического соединения с йодистым калием с последующим выделением йода, дающего с крахмалом синее окрашивание (ГОСТ , 1986).
Концентрацию молочной кислоты в супернатантах лактобактерий определяли энзиматическим колориметрическим методом с использованием тест-системы «Лактат-Витал» (Витал Диагностикс СПб, Россия).
Удаление метаболитов с молекулярной массой менее 1 kDa из супернатантов культур лактобактерий выполняли посредством диализа, используя диализные мембраны Spectra/Por MWCO 1000 (США).
Пептидный экстракт из супернатанта культуры E. faecium L3 получали путем преципитации 70% сульфатом аммония. Осадок, полученный после центрифугирования преципитированной суспензии, подвергали диализу (диализные мембраны Spectra/Por MWCO 1000, США). Содержимое диализного мешка фильтровали через мембрану Amicon PM (10000 MW, США) и концентрировали с помощью центрифугирования под вакуумом на установке Speed Vac Concentretor CS 18 (Savаnt Instruments Harvegetul 1993, США).
Концентрацию белка определяли по методу Флореса (Flores R., 1978).
Выделение и очистку низкомолекулярных катионных пептидных фракций культуры E. faecium L3 выполняли путем избавления пептидного экстракта от анионных примесей с помощью хроматографической колонки, заполненной карбоксиметилцеллюлозой CM 52 (Whatman, Англия), и последующего разделения фракций по молекулярной массе путем гельфильтрации на колонке с использованием Bio-Gel P10 (Bio-Rad). Антимикробную активность пептидных фракций определяли с помощью метода радиальной диффузии (Lehrer R. I. et al., 1991).
Анализ молекулярной массы пептидов, входящих в состав фракций, проводили с использованием электрофореза в полиакриламидном геле в присутствии додецил-сульфата натрия (Shagger H. et al., 1987).
Конструирование ДНК праймеров для ПЦР осуществляли с помощью программы PRIMER3 (http://www-genome. wi. mit. edu/cgi-bin/primer/primer3_www. cgi).
Анализ геномов лактобактерий на присутствие генов бактериоцинов выполняли путем выделения у бактерий ДНК и последующей постановки полимеразной цепной реакции. Экспрессию генов бактериоцинов в штамме E. faecium L3 подтверждали, используя метод обратной транскрипции.
Статистическую обработку данных проводили с использованием компьютерных программ Microsoft Excel и STATISTICA for Windows. Связь между категориями переменных анализировали с помощью t-критерия Стьюдента (сравнение средних значений в группах). Различия считали статистически значимыми при доверительном интервале 95% (p<0,05).
3. РЕЗУЛЬТАТЫ ИССЛЕДОВАНИЙ
3.1. Изучение особенностей роста пробиотических штаммов лактобактерий и их способности к продукции некоторых антимикробных факторов
Изучение особенностей роста используемых в работе штаммов молочнокислых бактерий показало, что они имели неодинаковую скорость роста. Максимальное нарастание биомассы было характерно для культуры L. plantarum 8Р-А3, а медленнее других росли штаммы L. acidophilus D75-76 и E. faecium М74. Остальные культуры демонстрировали среднюю скорость роста. Все исследуемые лактобациллы и энтерококки в процессе размножения вызывали сдвиг рН среды в кислую сторону. Среди культур антагонистов выделялись как сильные (L. plantarum 8Р-А3, L. acidophilus D75-76), так и слабые кислотообразователи (E. faecium М74). Скорость образования молочной кислоты также различалась и находилась в прямой зависимости от скорости роста лактобактерий. Так, например, в процессе выращивания L. plantarum 8Р-А3, характеризующейся быстрым нарастанием микробного числа, существенное закисление среды регистрировалось уже через 8 часов культивирования. С другой стороны медленнорастущая культура L. acidophilus D75-76, не изменявшая рН среды через 8 часов от начала инкубации, имела высокий уровень кислотообразования через 24 часа.
При определении молочной кислоты в супернатантах культур лактобактерий была установлена корреляция между уровнем продукции данного метаболита и значениями рН среды. Установлено, что все использованные антагонисты не продуцировали перекись водорода.
3.2. Выбор метода и подбор условий для изучения антимикробной активности молочнокислых бактерий
С целью изучения антагонизма живых пробиотических молочнокислых бактерий по отношению к патогенным стрептококкам и энтерококкам был выбран и модифицирован метод двухслойного агара, позволяющий выращивать на одной чашке микроорганизмы с различными питательными потребностями и осуществлять подсчет минимального ингибирующего количества антагониста (МИКА). В экспериментах с набором различных питательных сред было установлено, что антагонизм лактобактерий при исследовании методом двухслойного агара максимально проявлялся при использовании среды MRS в нижнем слое для культивирования антагонистов и колумбийского агара с добавлением 10% нормальной лошадиной сыворотки в верхнем слое для выращивания стрептококков и энтерококков. Были подобраны оптимальные условия для проведения экспериментов. Пробиотические культуры засевали в стационарной фазе роста (энтерококки после 24 часов и лактобациллы после 36 часов культивирования в жидкой среде MRS). Антагонисты добавляли в нижний слой агара в различных концентрациях (0-9 lg КОЕ/мл) и инкубировали при температуре 37оС в аэробных условиях в течение 24 часов. Затем индикаторные культуры, находящиеся в стационарной фазе, вносили в верхний слой агара по 10 мкл в количестве 6 lg КОЕ/мл и продолжали инкубацию в тех же условиях. Учет результатов осуществляли через 24 часа после посева индикаторных культур, определяя МИКА (минимальное ингибирующее количество антагониста), при котором рост чувствительных бактерий верхнего слоя среды полностью подавлялся.
3.3. Изучение антагонизма пробиотических культур в отношении патогенных стрептококков и энтерококков
Методом двухслойного агара, модифицированного нами, изучено антагонистическое действие шести штаммов лактобацилл и энтерококков по отношению к 40 штаммам Streptococcus spp. (по 10 штаммов серологических групп А, В, С и G) и 10 штаммам Enterococcus spp. Анализ результатов активности пробиотических культур в отношении стрептококков группы А (рис. 1) достоверно установил, что лактобактерии проявляли неодинаково выраженную способность ингибировать рост отдельных штаммов S. pyogenes, а сами штаммы стрептококков отличались по чувствительности к действию одного и того же антагониста. Аналогичные закономерности были получены при изучении антагонизма лактобактерий в отношении стрептококков серогрупп В, С и G и энтерококков.
При сравнительном анализе полученных результатов впервые были отмечены общие тенденции в показателях МИКА для стрептококков, относящихся к определенным серологическим группам. Максимальное антимикробное действие лактобактерий проявлялось по отношению к штаммам S. pyogenes, для которых среднее значение показателей МИКА составило 1,19 lg КОЕ/мл. Наибольшую резистентность проявляли штаммы S. agalactiae (серогруппа В), среднее значение МИКА для которых составляло 4,15 lg КОЕ /мл. Стрептококки серологических групп C и G обладали промежуточной чувствительностью к действию антимикробных факторов молочнокислых бактерий, средние значения МИКА для них определялись как 2,66 и 3,46 lg КОЕ/мл, соответственно.
Антагонистический эффект пробиотических культур по отношению к энтерококкам был выражен слабее, чем к стрептококкам. Для подавления их роста требовалась довольно большая концентрация бактерий антагонистов. Среднее значение МИКА для энтерококков составило 5,02 lg КОЕ/мл. Вместе с тем колебания данного показателя широко варьировали (от 2,14 до 7,05 lg КОЕ /мл).

А

Б
Рис. 1. Антагонистическая активность молочнокислых бактерий по отношению к различным штаммам S. pyogenes: А – МИКА энтерококков, Б – МИКА лактобацилл
Примечание: * - р<0,05
В настоящем исследовании было показано, что пробиотические штаммы в разной мере проявляют свою антагонистическую активность в отношении отдельных штаммов патогенных стрептококков и энтерококков. При этом не было установлено прямой взаимосвязи между силой антагонизма пробиотических культур, скоростью их роста и уровнем продукции данными культурами молочной кислоты. Так, например, культура L. plantarum 8Р-А3 с максимальной скоростью роста и высоким уровнем кислотообразования, в ряде случаев проявляла меньшую антагонистическую активность по сравнению с другими пробиотическими штаммами.
При совместном выращивании двух пробиотических культур общее количество бактерий, необходимое для подавления роста индикаторных штаммов, как правило, приближалось к показателю МИКА монокультуры более сильного антагониста или имело промежуточное значение. При этом было показано, что использованные пробиотические штаммы не проявляли выраженного антагонизма по отношению друг к другу. Ни в одном случае не было выявлено ослабления антимикробного эффекта при использовании смешанных культур лактобактерий. Кроме того, у отдельных индикаторных штаммов было отмечено значительное повышение чувствительности при сочетанном действии двух антагонистов. Добавление к пробиотической культуре супернатанта другого антагониста или супернатанта чувствительной культуры не вызывало достоверных изменений в антагонистической активности молочнокислых бактерий по отношению к патогенным стрептококкам или энтерококкам.
3.4. Изучение влияния супернатантов молочнокислых пробиотических бактерий на рост патогенных стрептококков
При использовании метода двухслойного агара добавление в нижний слой среды не живой культуры антагониста, а только его супернатанта, приводило к значительному снижению антимикробного эффекта. Ингибирующее действие таких супернатантов молочнокислых бактерий проявлялось лишь в отношении наиболее чувствительных штаммов S. pyogenes. В то же время при наблюдении за ростом стрептококков или энтерококков в жидкой питательной среде удалось выявить антимикробный эффект супернатантов лактобактерий в отношении всех используемых в работе индикаторных штаммов. У этих микроорганизмов обнаружены штаммовые, а у стрептококков еще и групповые, особенности в чувствительности к антимикробному действию супернатантов молочнокислых бактерий. Полученные результаты коррелировали с итоговыми данными по изучению антагонизма живых пробиотиков. Однако в отличие от живых лактобактерий полного подавления роста стрептококков супернатантами не наблюдалось ни в одном случае. Таким образом, результаты проведенных экспериментов указывают на то, что активность живых пробиотических культур существенно превосходит активность их метаболитов.
Отмечалась взаимосвязь между ростовыми особенностями индикаторных культур и степенью их чувствительности к совокупности антимикробных факторов молочнокислых бактерий. Как правило, штаммы, растущие менее интенсивно, демонстрировали более высокую чувствительность. Так штаммы стрептококков группы А (S. pyogenes), растущие медленнее, чем штаммы других серологических групп, проявляли максимальную чувствительность к ингибирующему действию супернатантов лактобактерий. А стрептококки группы В (S. agalactiae), обладающие более интенсивным ростом, в присутствии супернатантов тех же пробиотических культур, как правило, подавлялись в меньшей степени (рис. 2). В то же время некоторые медленнорастущие штаммы индикаторных стрептококков обнаруживали устойчивость к действию супернатантов молочнокислых культур; и наоборот, рост отдельных интенсивно растущих индикаторных  культур в значительной степени ингибировался супернатантами лактобактерий (рис.3).
культур в значительной степени ингибировался супернатантами лактобактерий (рис.3).
Рис. 2. Влияние супернатанта культуры E. faecium L3 на рост S. pyogenes и S. agalactiae (средние значения): Ак, Вк – контроль роста S. pyogenes и S. agalactiae, Ас, Вс – рост S. pyogenes и S. agalactiae в присутствии супернатанта
Примечание: * - р<0,05

Рис. 3. Влияние супернатанта культуры E. faecium L3 на рост штаммов S. agalactiaе: В14с, В16с – рост штаммов S. agalactiaе 14 и 16 в присутствии супернатанта; В14к, В16к – контроль роста штаммов S. agalactiaе 14 и 16
Примечание: * - р<0,05

 Наблюдаемые штаммовые особенности были ярче выражены в первые часы роста, когда бактерии находились в фазе адаптации. В это время антимикробное действие супернатантов, полученных из культур лактобактерий с примерно одинаковыми уровнями кислотообразования (например, E. faecium L3 и E. faecium SF68), могло существенно различаться (рис. 4). Однако уже через 8 часов культивирования эти различия заметно уменьшались.
Наблюдаемые штаммовые особенности были ярче выражены в первые часы роста, когда бактерии находились в фазе адаптации. В это время антимикробное действие супернатантов, полученных из культур лактобактерий с примерно одинаковыми уровнями кислотообразования (например, E. faecium L3 и E. faecium SF68), могло существенно различаться (рис. 4). Однако уже через 8 часов культивирования эти различия заметно уменьшались.
|
А
Рис. 4. Влияние супернатантов культур E. faecium L3 (А) и E. faecium SF68 (B) на рост различных штаммов S. pyogenes после 2-х часов инкубации
На основании полученных результатов мы предположили, что на начальных сроках инкубации индикаторных штаммов с супернатантами лактобактерий доминировало влияние антимикробных факторов, которые обладали выраженной активностью лишь в отношении отдельных штаммов стрептококков и не были одинаковыми у исследуемых штаммов антагонистов.
3.5. Изучение природы антимикробной активности супернатантов молочнокислых культур
При исследовании природы антимикробной активности супернатанта культуры E. faecium L3, проявлявшей выраженный антагонизм к ряду индикаторных бактерий, было показано, что значительную роль в подавлении роста стрептококков в системе in vitro играли метаболиты данного штамма с молекулярной массой меньше 1 kDa (рис. 5). Вместе с тем из пептидного экстракта, полученного из супернатанта культуры E. faecium L3, было выделено несколько низкомолекулярных (3-6 kDa) катионных пептидных фракций, способных в значительной степени ингибировать рост S. agalactiae (рис. 6).

Рис. 5. Влияние супернатанта культуры E. faecium L3, из которого путем диализа были удалены метаболиты, имеющих молекулярную массу менее 1 kDa, на рост S. agalactiaе (штамм В13): SL3 – супернатант, SL3+Д – супернатант после диализа, К – контроль роста S. agalactiaе В13
Примечание: * - р<0,05
Рис. 6. Антимикробное действие низкомолекулярных (3-6 kDa) пептидных фракций культуры E. faecium L3 по отношению к S. agalactiae (штамм B13)
Рис. 6. Антимикробное действие низкомолекулярных (3-6 kDa) пептидных фракций культуры E. faecium L3 по отношению к S. agalactiae (штамм B13)
Учитывая антимикробную активность некоторых пептидных фракций, полученных из супернатанта культуры E. faecium L3, а также их физико-химические свойства, было сделано предположение, что данные фракции могли содержать бактериоцины.
3.6. Исследование способности пробиотических энтерококков и лактобацилл к продукции бактериоцинов
При исследовании геномов пробиотических энтерококков и лактобацилл на наличие генов 8 бактериоцинов в штамме E. faecium L3 были обнаружены гены, кодирующие энтероцины А (entA) и В (entB). Ранее была изучена генетическая организация энтероцинов А и В и показано, что их продукция контролируется трехкомпонентной регуляторной системой, включающей пептид-индуктор, гистидиновую протеинкиназу и регулятор ответа (Nes I. F. et al., 2007). С помощью сконструированных на основании данных литературы дополнительных специфичных праймеров в геноме штамма E. faecium L3 были выявлены ген белка устойчивости к энтероцину А (entI), ген гистидиновой протеинкиназы - рецептора пептида-феромона (ent K) и ген белка устойчивости к энтероцину В (eniB). Полученные результаты свидетельствуют, что организация регулонов энтероцинов А и В у исследуемого штамма L3 аналогична ранее описанной у других штаммов E. faecium.
Чтобы подтвердить транскрипцию идентифицированных генов, из клеток культуры E. faecium L3 выделяли тотальную РНК и проводили обратную транскрипцию (ОТ). Анализ выделенной РНК с помощью ОТ-ПЦР, показал присутствие в мРНК фрагментов, соответствующих генам entА, entI, entK, entВ и eniB, что доказывало транскрипцию этих генов в штамме E. faecium L3 (рис. 7).

Рис. 7. Электрофорез ампликонов, полученных в результате проведения ОТ-ПЦР РНК культуры E. faecium L3:
1 – еntA, 2 – еntI, 3 – еntK, 4 – еntB, 5 – еniB, 6 – маркер молекулярного веса ( н. п.)
Таким образом, в результате проведенных молекулярно-генетических исследований в отношении пробиотического штамма E. faecium L3 была доказана транскрипция генов, ответственных за продукцию энтероцинов А и В.
3.7. Влияние синтетических пептидов-индукторов на антагонистическую активность молочнокислых бактерий
В настоящей работе было показано, что внесение в культуральную среду химически синтезированных специфичного пептида-индуктора (Pher-2) и его неполных структурных гомологов (Pher-1 и Pher-3) значительно повышало антагонистическую активность штамма E. faecium L3. Действие этих индуцирующих факторов оказалось высоко специфичным, так как антимикробная активность штаммов энтерококков, у которых не было обнаружено генов энтероцинов А и В, в присутствии синтезированных пептидов-индукторов не изменялась. Антагонистическая активность культуры E. faecium L3 после добавления феромонов и их производных, существенно усиливалась не только по отношению к листериям, обычно высокочувствительным к действию энтероцинов А и В, но также и к стрептококкам (рис. 8).

Рис. 8. Влияние супернатантов, полученных из культуры E. faecium L3, на рост S. agalactiae B13: К-B13 – контроль роста стрептококков, S-K – обычный супернатант, Pher – супернатант, полученный после добавления синтетического индуктора Pher-2
Примечание: * - р<0,05
Минимальное количество пептида Pher-2, индуцирующего синтез энтероцинов в штамме E. faecium L3 при добавлении в культуральную среду, составляло 10-11 M, в то время как гомологичные ему пептиды Pher-1 и Pher-3 работали в значительно большей концентрации (10-6 M). Биологический эффект ничтожно малых концентраций феромона подчеркивает специфичность механизмов синтеза и действия бактериоцинов. В данной работе впервые показано, что синтетические пептиды Pher-1 и Pher-3, состоящие из меньшего, чем природный феромон, количества аминокислотных остатков, но имеющие с ним общую циклическую последовательность (Cys-Val-Phe-Ser-Leu-Phe-Lys-Lys-Cys), также обладают способностью индуцировать синтез энтероцинов А и В в штамме E. faecium L3.
ВЫВОДЫ
1. Выявлены различия в чувствительности штаммов патогенных стрептококков и энтерококков к антагонистическому действию пробиотических молочнокислых бактерий (лактобацилл и энтерококков). Антагонизм лактобактерий наиболее выражен в отношении штаммов патогенных стрептококков группы А, наименее - стрептококков группы В и энтерококков.
2. Метод двухслойного агара, в предложенной модификации, позволяет проводить качественную и количественную оценку антимикробной активности молочнокислых бактерий в отношении стрептококков различных серологических групп.
3. Пептидные фракции с молекулярной массой 3-6 kDa, полученные из супернатанта культуры E. faecium L3, обладают выраженной антимикробной активностью, характерной для бактериоцинов.
4. В геноме штамма E. faecium L3 присутствуют транскрибируемые гены энтероцинов А и В и гены регуляторной системы, включающей пептид-индуктор (феромон), гистидиновую протеинкиназу и регулятор ответа.
5. Добавление в среду культивирования искусственно синтезированных специфичного пептида-индуктора и его гомологов существенно повышает антагонистическую активность пробиотического штамма E. faecium L3 в отношении индикаторных культур патогенных стрептококков в системе in vitro.
Список опубликованных работ по теме диссертации:
1. Yermolenko E., Chernysh A., Martsinkovskaya I., Suvorov A. In vitro study of antagonistic activity of lactic acid bacteria // 1st International Conference on Environmental, Industrial and Applied Microbiology (BioMicroWorld-2005), Badajoz, Spain, 15-18 March 2005.-P.218.
2. Yermolenko E., Suvorov A., Chernysh A., Aleshina G., Cvetkova E., Martsinkovskaya I., Totolyan A. Antagonistic activity of Enterococcus faecium L3 against different groups of pathogenic streptococci // The XVI Lancefield International Symposium on Streptococci and Streptococcal Diseases, Palm Cove, Australia, 25-29 September 2005.-P.183.
3. , , Суворов активность энтерококков и лактобацилл при раздельном и совместном культивировании in vitro // Материалы 7-го Международного Славяно-Балтийского научного форума в журнале «Гастроэнтерология Санкт-Петербурга». -2005.-№1-2.-С. М47.
4. , , Суворов патогенных Enterococcus spp. к пробиотическим энтерококкам // Материалы Российской научно-практической конференции, посвященной 110-летию кафедры инфекционных болезней Военно-медицинской академии им. С.М. Кирова «Инфекционные болезни: проблемы здравоохранения и военной медицины», СПб, 22-24 марта 2006.-С.320.
5. Yermolenko E., Suvorov A., Chernysh A., Aleshina G., Cvetkova E., Martsinkovskaya I., Totolyan A. Antagonistic activity of Enterococcus faecium L3 against different groups of pathogenic streptococci // Streptococci – New Insight into an Old Enemy, May 2006.-P.363-366.
6. , , Тотолян пробиотических энтерококков на рост Streptococcus agalactiae // Журнал микробиологии, эпидемиологии и иммунологии. -2007.-№5.-С.73-77.
7. , , Суворов пробиотических энтерококков при лечении экспериментального кольпита, вызванного стрептококками группы В // Материалы IX съезда Всероссийского общества эпидемиологов, микробиологов и паразитологов, Москва, 26-27 апреля 2007. - С.298-299.
8. , , Суворов Enterococcus faecium L3 на рост стрептококков группы В // Материалы Международного конгресса «Пробиотики, пребиотики, синбиотики и функциональные продукты питания. Фундаментальные и клинические аспекты», СПб, 15-16 мая 2007. - С. А73.
9. , , Суворов активность энтерококков, связанная с выработкой энтероцинов // Материалы Международного конгресса «Пробиотики, пребиотики, синбиотики и функциональные продукты питания. Фундаментальные и клинические аспекты», СПб, 15-16 мая 2007. - С. A73.
10. , , Тотолян пептидов-индукторов на антимикробную активность энтерококков // Материалы 10-го Юбилейного Славяно-Балтийского научного форума «Санкт-Петербург – Гастро-2008», СПб.-14-16 мая 2008.-С. М127.
11. , , Суворов активность энтерококков в отношении Streptococcus pyogenes // Вестник Санкт-Петербургского Университета. -2008. -№1.-С.18-25.
12. Yermolenko E., Chernysh A., Kolobov A., Suvorov A. Antibacterial activity of enterococci induced by synthetic pheromons // International probiotic conference «Probiotics for the 3rd Millennium», High Tatras, Slovakia, 4-7 June 2008. - P.23S.
13. Rybalchenko O., Yermolenko E., Chernysh A., Suvorov A. The influence of probiotic lactic acid bacteriae on the morpho-physiological characteristics of group A streptococci // The XVII Lancefield International Symposium on Streptococci and Streptococcal Diseases, Porto Heli, Greece, 22-26 June 2008.-P.146.
14. Chernysh A., Yermolenko E., Kolobov A., Suvorov A., Totolyan A. Influence of synthetic peptide inductors on antibacterial activity of enterococci // The XVII Lancefield International Symposium on Streptococci and Streptococcal Diseases, Porto Heli, Greece, 22-26 June 2008.-P.370.




